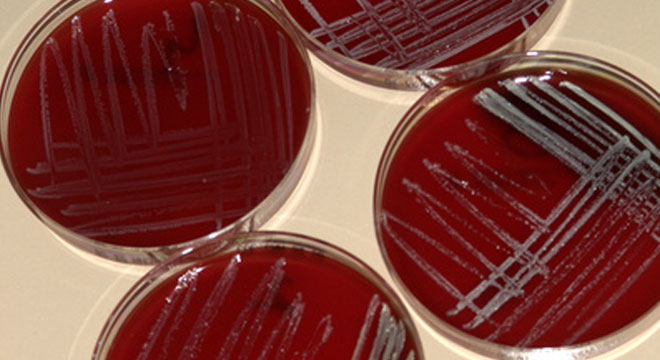

Was ist eine Bakterienkultur
Eine Bakterienkultur dient zum Nachweis von Bakterien, meist im Zusammenhang mit einer Infektion. Dafür wird vom Patienten Untersuchungsmaterial (Abstrich oder Sekrete) entnommen, welches die vermeintlichen Bakterien enthält. Im Labor werden die Bakterien zur genauen Keimbestimmung über Nacht im Brutschrank als Bakterienkultur angezüchtet und auf ihre Antibiotika-Empfindlichkeit geprüft (Antibiogramm). Damit kann man feststellen, auf welche Antibiotika der Keim empfindlich bzw. unempfindlich (resistent) ist. Dies ist vor allem bei seltenen Keimen oder ernsthaften Infektionen wichtig, um die optimale antibiotische Behandlung durchzuführen.Die Bakterienkultur ist eine Untersuchung aus der Mikrobiologie und Infektiologie, einem Teilgebiet der Inneren Medizin.
Bedarf es einer speziellen Vorbereitung auf die Untersuchung
Ein Abstrich kann ohne besondere Vorbereitung durchgeführt werden. Er sollte möglichst vor Anwendung von Desinfektionsmitteln oder Antibiotika erfolgen.
Was wird vor der Untersuchung abgeklärt
Vor einer Bakterienkultur ist keine spezielle Abklärung notwendig.Wie wird eine Bakterienkultur durchgeführt
Das Untersuchungsmaterial stammt meist von Abstrichen (z.B. Wundinfektionen), aus dem Blut oder von Körpersäften (Sekrete) wie Speichel, Magensaft, Urin, Stuhl, Eiter, Vaginalsekret oder Rückenmarksflüssigkeit. Das Material wird im Labor zunächst direkt unter dem Mikroskop betrachtet. Dazu wird es vorher mit speziellen Farbstoffen gefärbt, um bestimmte Bakterienarten besser zu erkennen.
Für die Bakterienkultur wird das Material auf speziellen Nährböden in einem Brutschrank bei einer Temperatur von 37 Grad Celsius (Körpertemperatur) gelagert. Meist dauert es mehrere Tage bis eine Bakterienkultur ausreichend gewachsen ist um gut sichtbar zu sein. Viele Keime lassen sich bereits am typischen Wachstum und Aussehen (Farbe) der Kolonie oder unter dem Mikroskop erkennen. Andere wiederum werden mit speziellen laborchemischen Analysemethoden identifiziert.
Für das Antibiogramm befinden sich auf der Platte, auf der die Bakterienkultur wächst, kleine Filzplättchen, die mit verschiedenen Antibiotika getränkt sind. Damit lässt sich feststellen, welches Antibiotikum am besten das Bakterienwachstum hemmt, da die Zone um das Filzplättchen frei von der Kolonie bleibt. Je grösser die Zone, desto stärker ist die bakterienhemmende Wirkung des jeweiligen Antibiotikums.
Wann wird eine Bakterienkultur eingesetzt
Eine Bakterienkultur dient zur Bestimmung der Keime bei bakteriellen Infektionen. Aber nicht jede Infektion bedarf einer Bakterienkultur. Wichtig ist sie vor allem bei schweren Infektionen oder seltenen Keimen oder wenn eine antibiotische Behandlung nicht ausreichend wirkt.
Hat die Bakterienkultur Nebenwirkungen
Diese Untersuchung ist schmerzlos und ohne Risiken.